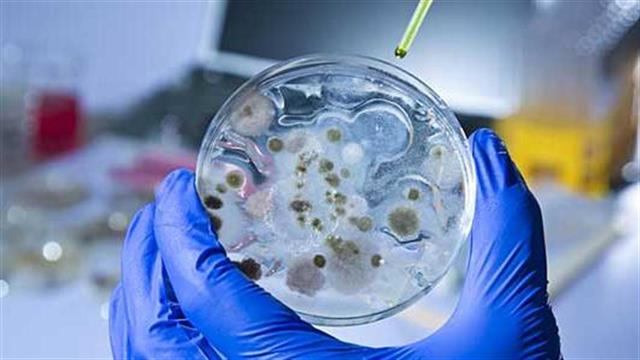
Δεν πάσχει από ‘Εμπολα το περιστατικό στη Δανία

Εργαζόμενος στον τομέα της υγείας που επέστρεψε στη Δανία από τη δυτική Αφρική δεν πάσχει από τον ιό ‘Εμπολα, ανακοίνωσε αξιωματούχος του νοσοκομείου στο οποίο νοσηλεύεται.
Η ανακοίνωση ακολούθησε εξετάσεις που πραγματοποιήθηκαν καθώς ο ασθενής, που θεωρήθηκε ύποπτο περιστατικό για ‘Εμπολα, ανέφερε ελαφρά άνοδο της θερμοκρασίας του.
Το τεστ είναι αρνητικό, δήλωσε ο αξιωματούχος για την εξέταση.
Πηγές:
Ξένος τύπος.
Ειδήσεις υγείας σήμερα
Ξενάγηση στο εργοτάξιο του Παιδιατρικού Νοσοκομείου Θεσσαλονίκης ΙΣΝ
Αλκοόλ: Τι προκαλεί στα οστά
Νέα επένδυση στα τρόφιμα από την οικογένεια Σκλαβενίτη
ECDC - Πιθανότητα για ένα κρούσμα 'Εμπολα σε κάθε 24.000 ταξιδιώτες που φτάνουν στην Ευρώπη
ECDC - Πιθανότητα για ένα κρούσμα 'Εμπολα σε κάθε 24.000 ταξιδιώτες που φτάνουν στην Ευρώπη ECDC: 'Εως 10,2 φορές περισσότερα τα κρούσματα Έμπολα από όσα δηλώνονται
ECDC: 'Εως 10,2 φορές περισσότερα τα κρούσματα Έμπολα από όσα δηλώνονται ECDC: 0,45% η πιθανότητα μετάδοσης κρούσματος Έμπολα στην Ευρώπη έως τις 25 Ιουνίου
ECDC: 0,45% η πιθανότητα μετάδοσης κρούσματος Έμπολα στην Ευρώπη έως τις 25 Ιουνίου Έμπολα στη ΛΔ Κονγκό: Αυξάνονται τα κρούσματα και επεκτείνεται η επιδημία σε νέες περιοχές
Έμπολα στη ΛΔ Κονγκό: Αυξάνονται τα κρούσματα και επεκτείνεται η επιδημία σε νέες περιοχές Κονγκό: Σχεδόν 600 επιβεβαιωμένα κρούσματα Έμπολα
Κονγκό: Σχεδόν 600 επιβεβαιωμένα κρούσματα Έμπολα CDC: Ανησυχία για ανεξέλεγκτη εξάπλωση του Έμπολα
CDC: Ανησυχία για ανεξέλεγκτη εξάπλωση του Έμπολα Ξενάγηση στο εργοτάξιο του Παιδιατρικού Νοσοκομείου Θεσσαλονίκης ΙΣΝ
Ξενάγηση στο εργοτάξιο του Παιδιατρικού Νοσοκομείου Θεσσαλονίκης ΙΣΝ Διαταραχές πρόσληψης τροφής: 1.000 περίπου περιστατικά τον χρόνο - Δεν επαρκούν οι δομές
Διαταραχές πρόσληψης τροφής: 1.000 περίπου περιστατικά τον χρόνο - Δεν επαρκούν οι δομές ΒΙΑΝΕΞ: Νέο κέντρο έρευνας και ανάπτυξης στη Πάτρα
ΒΙΑΝΕΞ: Νέο κέντρο έρευνας και ανάπτυξης στη Πάτρα Λάθη που μειώνουν την απορρόφηση βιταμίνης D από συμπληρώματα
Λάθη που μειώνουν την απορρόφηση βιταμίνης D από συμπληρώματα Με ποιες τροφές να συνδυάζω ρύζι, πατάτες και ζυμαρικά για να μην αυξάνεται απότομα το σάκχαρο
Με ποιες τροφές να συνδυάζω ρύζι, πατάτες και ζυμαρικά για να μην αυξάνεται απότομα το σάκχαρο Ρύζι, πατάτες και ζυμαρικά: Ποιο είναι χειρότερο για το σάκχαρο;
Ρύζι, πατάτες και ζυμαρικά: Ποιο είναι χειρότερο για το σάκχαρο; Pharmathen: Βαθιά κρίση και μηδενισμός αποτίμησης από funds της Partners
Pharmathen: Βαθιά κρίση και μηδενισμός αποτίμησης από funds της Partners Φαρμακοβιομηχανίες σκέφτονται να χτυπήσουν την πόρτα της Εθνικής Αρχής Διαφάνειας
Φαρμακοβιομηχανίες σκέφτονται να χτυπήσουν την πόρτα της Εθνικής Αρχής Διαφάνειας Καρπούζι: Ποια είναι τα οφέλη του στην υγεία
Καρπούζι: Ποια είναι τα οφέλη του στην υγεία "Οδύσσεια" η αναζήτηση ασφαλούς φαγητού για άτομα με κοιλιοκάκη [ελληνική μελέτη]
"Οδύσσεια" η αναζήτηση ασφαλούς φαγητού για άτομα με κοιλιοκάκη [ελληνική μελέτη] ΕΟΠΥΥ: Στο 1,1 δισ. ευρώ έκλεισαν clawback - rebate φαρμάκων το 2025 - Επίσημος απολογισμός
ΕΟΠΥΥ: Στο 1,1 δισ. ευρώ έκλεισαν clawback - rebate φαρμάκων το 2025 - Επίσημος απολογισμός Απ. Παπαλάκης: Ραγδαία αύξηση περιστατικών καρκίνου της ουροδόχου κύστης
Απ. Παπαλάκης: Ραγδαία αύξηση περιστατικών καρκίνου της ουροδόχου κύστης